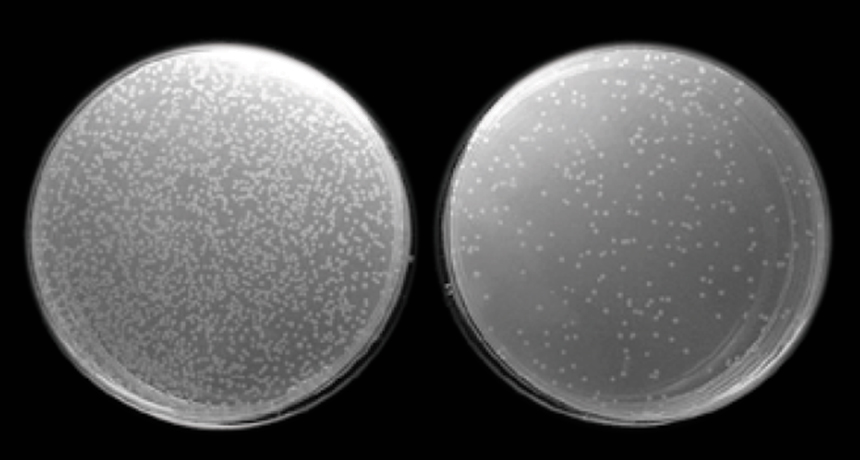
Immune cells

Rewarding stimulation boosts immune system
Experiment in mice may help explain placebos’ power
TWO TALES Immune cells taken from mice that had their brains’ reward systems activated (right) killed more E. coli than immune cells taken from control mice (left).
T.L. Ben-Shaanan et al/Nature Medicine 2016







